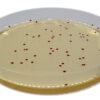
Хромогенне середовище для виявлення термотолерантного Campylobacter / CHROMagarтм Campylobacter

24930000-2 Фотохімікати
Назва категорії: Живильні середовищаОдиниці виміру: штука
Технічні характеристики
Вид
Відповідність ДСТУ EN ISO 11133:2014
Фасування
Основа складу
Знайдено: 253

Емульсія яєчного жовтка / EGG YOLK EMULSION, Sanimed-M

Агар Байд-Паркера, з телуритом 3,5%, селективнинй компонент

Лактозо – пептоне середовище/LACTOSE PEPTONE BROTH, Sanimed-M

Бульйон з лізином для аналізу декарбоксилації / DECARBOXYLASE BROTH WITH LYSINE, Sanimed-M

Бульйон Фрейзера, основа

Середовище Гісса з сорбітом / GISSA AGAR W/ SORBITOL, Sanimed-M

Бульйон Фрейзера вторинного збагачення, 4015962+4240056
Хромогенне середовище для виявлення термотолерантного Campylobacter / CHROMagarтм Campylobacter

Агар Сабуро з хлорамфеніколом, 100 мкг Sanimed-M

Селенітовий бульйон Лейфсона / SELENIT BROTH LEYFSON, Sanimed-M

Пептон лужний (основний) / ALKALINE PEPTONE, Sanimed-M
